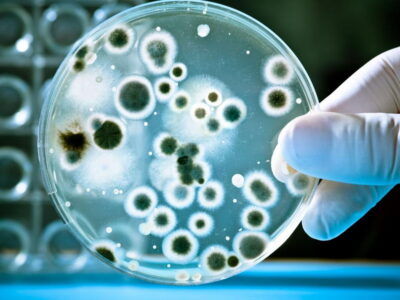
очистка воды от бактерий и вирусов

Сколько воды должен пить ребенок?
Жаркое лето, яркое палящее солнце и активная работа потовых желез ребенка жаждут нормализации водного баланса организма. Обезвоживание детского организма может привести к ухудшению самочувствия и к серьезным последствиям для здоровья. Именно поэтому, ежедневно, в течении всего дня, ребенку следует пить как можно больше жидкости. Тем не менее многие родители задаются вопросом:...